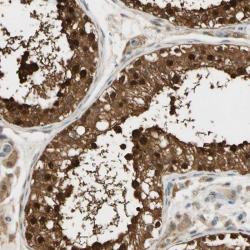

sc-863
antibody from Santa Cruz Biotechnology
Targeting: RASGRF1
CDC25, CDC25L, GNRP, GRF1, GRF55, H-GRF55, PP13187
Antibody data
- Antibody Data
- Antigen structure
- References [1]
- Comments [0]
- Validations
- Immunohistochemistry [1]
Submit
Validation data
Reference
Comment
Report error
- Product number
- sc-863 - Provider product page

- Provider
- Santa Cruz Biotechnology
- Proper citation
- Santa Cruz Biotechnology Cat#sc-863, RRID:AB_2238127
- Product name
- Anti-RASGRF1
- Antibody type
- Polyclonal
- Antigen
- Recombinant full-length protein
- Reactivity
- Human
- Host
- Rabbit
Submitted references The Ras guanine nucleotide exchange factor RasGRF1 promotes matrix metalloproteinase-3 production in rheumatoid arthritis synovial tissue.
Abreu JR, de Launay D, Sanders ME, Grabiec AM, van de Sande MG, Tak PP, Reedquist KA
Arthritis research & therapy 2009;11(4):R121
Arthritis research & therapy 2009;11(4):R121
No comments: Submit comment
Supportive validation
- Submitted by
- per
- Main image
- Experimental details
- Immunohistochemical staining of human testis shows strong nuclear and cytoplasmic positivity in cells of seminiferus ducts.
- Validation comment
- No experimental and/or bioinformatic data available, or staining pattern not consistent with experimental and/or bioinformatic data.